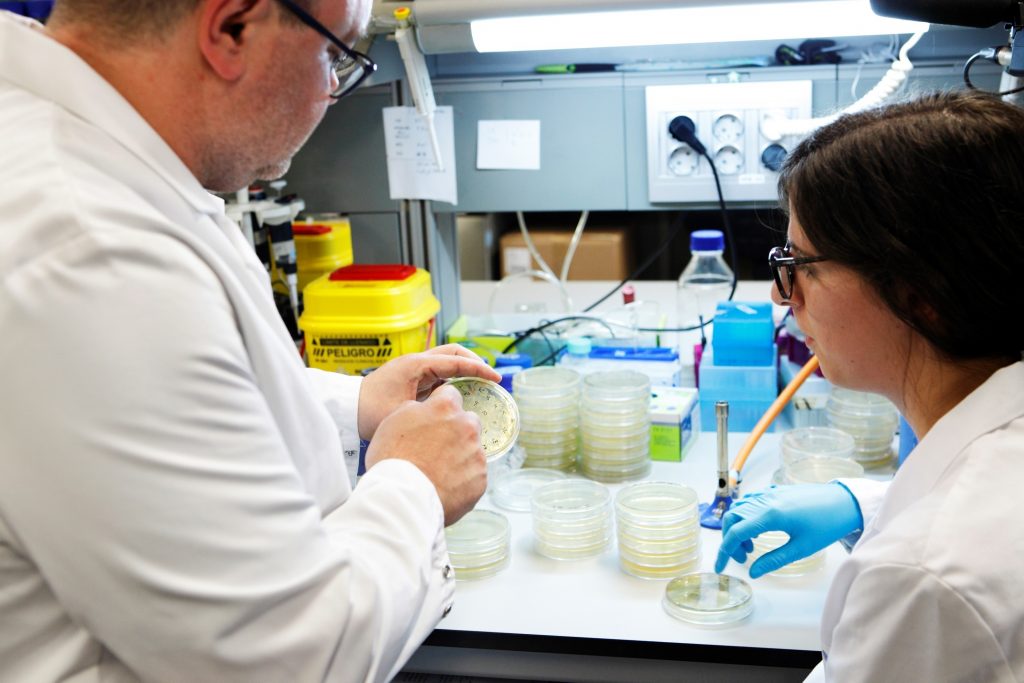

31.01.2017 - 15:00
BARCELONA, 31 (EUROPA PRESS)
La tercera convocatòria del programa CaixaImpulse per potenciar la creació d’empreses biotecnològiques començarà aquest dimecres 1 de febrer ampliant els beneficiaris de 20 a 23 i sumant Portugal, mentre que fins ara se centrava a Espanya.
Es tracta d’una iniciativa de l’Obra Social La Caixa i Caixa Capital Risc en què aquest any també col·labora EIT Health, consorci europeu de més de 144 empreses, universitats i centres d’investigació líders en innovació, biomedicina i salut, ha informat la Fundació La Caixa en un comunicat aquest dimarts.
Fins al 15 de març, es poden presentar al programa projectes de l’àmbit de les ciències de la vida i de la salut procedents de centres d’investigació espanyols i portuguesos que siguin propietaris o copropietaris d’actius protegits o en procés de protecció.
CaixaImpulse busca afavorir que el coneixement científic originat en centres d’investigació, universitats i hospitals es transformi en empreses i productes que generin valor a la societat, tant en la forma d’un acord de transferència com d’una empresa (‘spin-off’).
Aquesta convocatòria té un pressupost de més de dos milions d’euros, i els projectes seleccionats rebran una ajuda econòmica de fins a 70.000 euros dirigida a definir i executar un pla de valorització de la tecnologia amb les màximes probabilitats d’èxit.
També tindran accés a un programa d’acompanyament expert de vuit mesos, valorat en 300.000 euros, de la mà de mentors, especialistes, emprenedors i formadors de prestigi internacional.